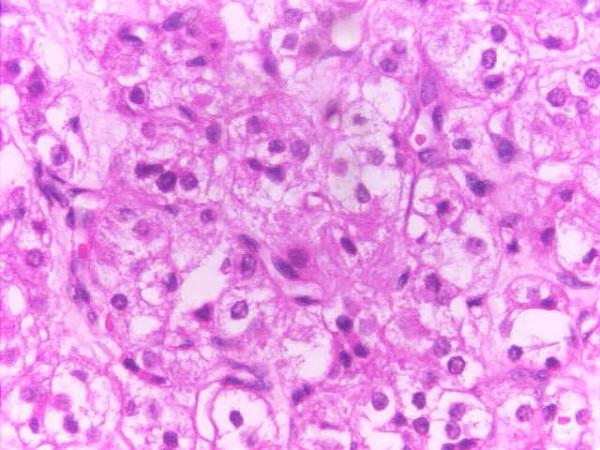
https://cdn.ncbi.nlm.nih.gov/pmc/blobs/f627/2231374/2e0c2b7343f2/1752-1947-1-182-2.jpg

一名年轻哺乳期女性突发严重高雄激素血症,患卵巢雄激素分泌性类固醇细胞瘤:病例报告及文献复习
Androgen secreting steroid cell tumor of the ovary in a young lactating women with acute onset of severe hyperandrogenism: a case report and review of literature.
作者信息
Haji Altaf Gauhar, Sharma Shekhar, Babu Manoj, Vijaykumar Dk, Chitrathara K
机构信息
Department of Surgical Oncology, Amrita Institute of Medical Sciences and Research Centre, Edapally, Kochi, Pin-682026, Kerela, India.
出版信息
J Med Case Rep. 2007 Dec 18;1:182. doi: 10.1186/1752-1947-1-182.
INTRODUCTION
Steroid cell tumors of the ovary account for less than 0.1% of all ovarian tumors 1 and these tumours may present at any age in association with interesting presentations related to the hormonal activity and virilizing properties of tumor. Hayes and Scully 2 reported 63 cases in patients ranging from 2 to 80 years of age. The subtype, not otherwise specified, is associated with androgenic changes in approximately one half of patients with this tumour 1. In a series of 63 cases from Massachusetts General Hospital, 94% of the tumors were found to be unilateral and 28.6% were malignant 3. As most of these tumors are diagnosed at an early stage and do not recur or metastasize, little is known about their response to therapies such as chemotherapy or radiation 3.
CASE PRESENTATION
We present the case of a 22-year old lactating woman who presented with four months of amenorrhea associated with signs of virilization. Clinical and diagnostic evaluation revealed a right adenexal mass and elevated serum levels of testosterone and she was diagnosed as having a stage 1A androgen secreting steroid cell tumor. In view of the early stage of the disease, she underwent right salpingo-oopherectomy. Histopathological examination and immunohistochemistry confirmed the diagnosis. Two months after surgery she regained normal menses and showed regression of the androgenic changes.
CONCLUSION
Surgery remains the mainstay of the treatment of gonadotrophin receptor positive steroid cell tumors although medical therapy using Gonadotrophin Releasing Hormone [GnRH analogues has been tried recently in recurrent or inoperable cases. There is no described effective chemotherapy or radiotherapy for this condition.
引言
卵巢类固醇细胞瘤占所有卵巢肿瘤的比例不到0.1%,这些肿瘤可在任何年龄出现,并伴有与肿瘤的激素活性和男性化特性相关的有趣表现。海斯和斯库利报告了63例患者,年龄从2岁到80岁不等。未另行指定的亚型在大约一半的该肿瘤患者中与雄激素变化有关。在麻省总医院的一系列63例病例中,94%的肿瘤为单侧性,28.6%为恶性。由于这些肿瘤大多在早期被诊断出来,且不复发或转移,因此对它们对化疗或放疗等治疗的反应了解甚少。
病例介绍
我们报告一例22岁哺乳期妇女,出现四个月闭经并伴有男性化体征。临床和诊断评估发现右侧附件包块以及血清睾酮水平升高,她被诊断为1A期分泌雄激素的类固醇细胞瘤。鉴于疾病处于早期,她接受了右侧输卵管卵巢切除术。组织病理学检查和免疫组化证实了诊断。手术后两个月,她月经恢复正常,男性化体征消退。
结论
手术仍然是促性腺激素受体阳性类固醇细胞瘤治疗的主要方法,尽管最近在复发或无法手术的病例中尝试了使用促性腺激素释放激素(GnRH)类似物的药物治疗。对于这种情况,尚无有效的化疗或放疗方法。